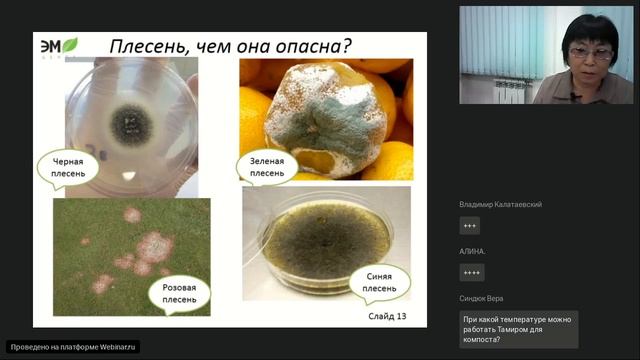
Избавляемся от плесени (методы) смотреть онлайн

Автор / Канал: Блеск с лучшими продуктами Страница 5

Серия класса люкс,это мой выбор!

Уход за кожей ног зимой

peeling apple was never this easy! This Working is very hard?

Дела Житейские | Предновогодние заботы о красоте

Restyline в «ЭСТЕЛАБ»

Серия NOVAGE от ОРИФЛЭЙМ, ваша кожа моложе чем вы .

Объедение на ужин за 30 минут - Хохоп из курицы
Избавляемся от плесени (методы)

Обзор заказа из Кореи / Атоми

Новинки каталожного периода Oriflame №4

197 Косметика Coverderm уходовые линейки

Как восстановить кожу после лета?

2. Взгляд со стороны хостинг-провайдера на опыт использования OpenVZ6

Darling pretty - The Pipers (M. Knopfler cover)

Секонд-Хенд • Придбання • Radley • Nunoom Jewelry • Fielmann

Beurer

Настольная игра - Мой калейдоскоп. Цветные узоры

Dove Exfoliating Body Polish

Подводный душ-массаж в клинике "Наука". Прямой эфир

Остановили за Тонировку. Смотри что Вышло.

Мой уход - очищение

НОВИНКА! Уникальная сила природы в системе Mary Kay Naturally. Микробиолог ЛБГ Инесса Шапошник.

Распаковка посылок Клиник и Тиана

НОВИНКИ В FIX PRICE/ЕСТЬ ЧТО КУПИТЬ!!!
За каждым успешным каналом стоит личность, идея и сотни часов кропотливого труда. Если вы здесь, значит, автор «Блеск с лучшими продуктами» уже сумел зацепить ваше внимание своим уникальным стилем или подачей. А мы на RUVIDEO позаботились о том, чтобы вы могли изучить весь архив его работ в максимально комфортных условиях — без лишней суеты и преград.
Почему за работами канала «Блеск с лучшими продуктами» так интересно наблюдать? Всё просто: это честный контент, который находит отклик в сердцах зрителей. На нашем ресурсе вы можете смотреть онлайн все видео любимого автора бесплатно и в хорошем качестве. Нам важно, чтобы вы видели каждую деталь и слышали каждый нюанс, поэтому мы используем только стабильные плееры из открытых источников Rutube.
Следите за новинками канала, пересматривайте старые шедевры и открывайте для себя новые грани творчества «Блеск с лучшими продуктами». Мы постоянно обновляем ленту, чтобы у вас под рукой всегда были самые свежие выпуски. Никаких сложных регистраций — только вы и творчество, которое вдохновляет. Приятного вам путешествия по миру авторского контента на RUVIDEO!
Видео взято из открытых источников Rutube. Если вы правообладатель, обратитесь к первоисточнику.